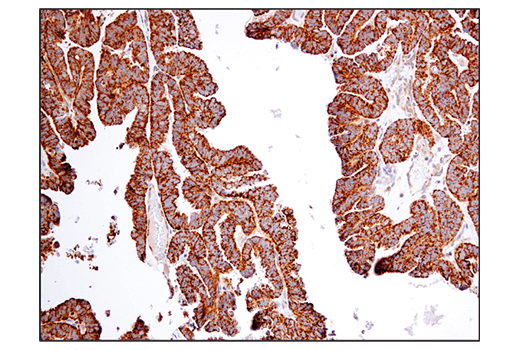

マイストア
変更
お店で受け取る
(送料無料)
配送する
納期目安:
2025.10.10 21:57頃のお届け予定です。
決済方法が、クレジット、代金引換の場合に限ります。その他の決済方法の場合はこちらをご確認ください。
※土・日・祝日の注文の場合や在庫状況によって、商品のお届けにお時間をいただく場合がございます。
B子 RCSB PDB - 8JZX: SLC15A4 inhibitor complexの詳細情報
RCSB PDB - 8JZX: SLC15A4 inhibitor complex。BCAT2 (D8K3O) Rabbit mAb | Cell Signaling Technology。BCAT2 (D8K3O) Rabbit mAb | Cell Signaling Technology。UJOH(ウジョー) Slit sleeve 別注シャツ | B'2nd(ビーセカンド。商品の説明はありません
ベストセラーランキングです
近くの売り場の商品
カスタマーレビュー
オススメ度 4.6点
現在、3576件のレビューが投稿されています。